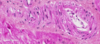

Coloration de base en histologie
H & E
Hématoxilyne-Éosine
De quoi est composé le H&E
Hématoxyline
Éosine
Qu’est-ce que l’hématoxyline?
Colorant basique qui a une affinité cellulaires chargés négativement (ou acides)
Que colore l’hématoxyline?
Les noyaux (acides nucléiques) –> violet / bleu
Qu’est-ce que l’étosine?
Colorant acide qui a une affinité pour les éléments cellulaires chargés positivement (ou basiques).
Que colore l’éosine?
Le cytoplasme et les autres éléments cellulaires basiques –> rose/rouge
Qu’est-ce que la coloration HES?
Hématoxyline - Éosine - Safran
Qu’est-ce que le safran?
Coloration acide qui lie les structures basiques du collagène
Exemple de structure comportant du collagène?
Matrice extracellulaire
Qu’est-ce que ça signifie quand il y a du blanc sur une lame?
C’est optiquement vide (lumière ou lipides dissous)
La coloration HES est __________.
Une coloration de routine.
Particularité du Triangle de Masson (bleu)?
Bleu d’aniline
Qu’est-ce que le bleu d’aniline?
Colorant acide qui lie les structures basiques du collagène et du mucus (les rend bleus)
La coloration Trichrome de Masson _____
Est une coloration spéciale
Les artefacts les plus fréquents?
-Globules rouges
-Espacement vide
-Plis
-Bulles
-Déchirures
-Adipocytes vides
-Dépôts
-Stries
Les globules rouges sont un problème de ________
Prélèvement (saignement)
L’espacement vide est un problème de _______
Fixation (rétrécissement), circulation (rétrécissement), bain d’étalement (expansion)
Les plis sont des problèmes de _______
-Coupe au microtome (forme circulaire du tissu)
-Bain d’étalement (température trop basse)
Les bulles sont un problème de ______
Montage de la lamelle (bulles dans le milieu de montage)
Les déchirures sont un problème de ______
-Coupe au microtome (couteau)
-Bain d’étalement (température trop élevée)
Les adipocytes vides sont un problème de _______
Circulation (dissolution des lipides)
Les dépôts sont des problèmes de ______
-Bain d’étalement (saletés)
-Coloration (précipités)
Les stries sont des problèmes de _____
Coupe au microtome (couteau usé / particule dure dans le tissu)
Quelles sont les incidences de coupe?
-Transversale
-Longitudinale
-Oblique